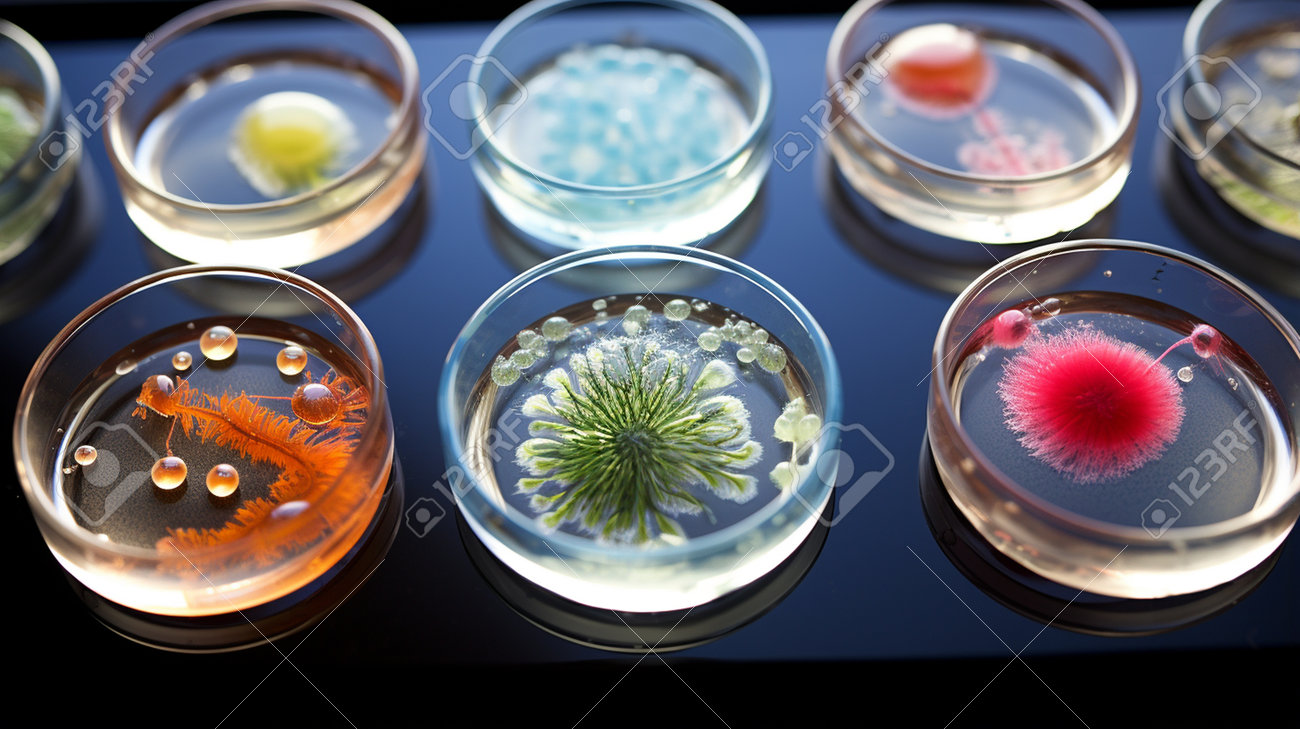
etiam-dictum-ipsum-a-felis

Download
Close
Автор:
id:
Ключевые слова:
background, bacteria, bacterium, biological, biology, biotechnology, cell, chemistry, education, experiment, glass, health, isolated, lab, laboratory, macro, medical, medicine, micro, microbiology, microscope, microscopic, organism, research, science, scientific, set, transparent, virus, white,





